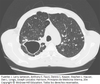

Mycobacterium tuberculosis Flashcards
(40 cards)
Estado de México con mayor incidencia de TB
Veracruz
Mecanismo de transmisión de M. Tuberculosis
A traves de las gotitas respiratorias aerolizadas e inhaladas por el paciente por medio de la tos, al estornudar o hablar.
Principal característica microbiológica que hace distinta a Mycobacterium del resto de las bacterias gram positivas y gram negativas
Mycobacterium es ácido-alcohol resistente. No se tiñe con tinción de gram.
No formador de esporas, aerobio estricto, no movil
Define la TB primaria
Se define como la infección clínica por mycobacterium tuberculosis inmediatamente tras la infección por el patógeno. Suele ocurrir comunmente en niños en los primeros años de vida y en inmunosuprimidos que no habian tenido contacto con el patógeno.
Define a la TB secundaria
Se define como la reactivación y traducción clínica de la primoinfección por mycobacterium que suele ocurrir años antes. Como resultado de un estado inmunosuprimido parcial/totalmente.
Es el factor de riesgo más importante para la traducción clínica de TB
Co-infección con HIV
Patogenia de la tuberculosis
- Infección del huesped por medio de gotitas respiratorias en aerosol
- Una fracción <10% de las gotitas inhaladas alcanzan el espacio alveolar
- Fagocitosis del mycobacterium por los macrófagos alveolares residentes
- Falla en la formación del complejo fagosoma-lisosoma dentro del macrófago que contiene al mycobacterium gracias a la inhibición del influjo de Ca2+ por la pared celular de lipoglicano-lipoarabinomanano
- Inhibición del autofagosoma para la destrucción del macrófago infectado por medio de factores bacterianos
- Inicio de replicación, eventual ruptura del macrofago infectado e invasión a otros macrófagos y diseminación a través de los ganglios linfáticos.
- Formación del granuloma temprano, maduración y formación de granuloma maduro (2-4 semanas despues).
- Acumulación de macrófagos, células epiteliales, PMNs, y linfocitos que produce una necrosis caseosa interna con bajos niveles O2 y pH ácido. Lo cual vuelve latente al Mycobacterium y detiene su replicación.
- Formación de la calcificación “sana”.
- En una minoría de casos ocurre una respuesta inflamatoria mediada por macrófagos debil desencadenando una reacción de hipersensibilidad retardada que produce la liberación del patógeno y diseminación hacia circulación venosa pulmonar y evntualmente hacia la circulación sistémica.
Son macrófagos fusionados que intentan contener la enfermedad y formando al granuloma, manifestando un núcleo periférico en forma de herradura

Células de Langhans
Paciente de 40 años, diabetes mellitus e HAS, IMC <25 kg/m2
Refiere iniciar con tos, fiebre nocturna asociada a sudoraciones profusas y falta de aire. Refiere del apetito y baja de peso. Se realiza la siguiente radiografía de tórax demostrando lo siguiente:

Es un complejo de Ghon: linfadenopatia parahiliar o bronquial en zonas/segmentos pulmonares inferiores o medios en paciente con primoinfección por TB
¿descripción de la placa y posible diagnóstico?

Es una cavitación en el lóbulo apical del pulmon derecho que sugiere infección por tuberculosis
muy probablemente es una TB secundaria o del adulto. Ya que es el sitio común donde se encuentran las cavitaciones.
Principales manifestaciones clínicas de TB secundaria o del adulto
Fiebre, sudoraciones nocturnas, pérdida de peso
Disnea, tos productiva mucopurulenta
Debilidad y malestar general (mialgias y artralgias)
Hemoptisis
Son las principales anormalidades hematológicas observadas en TB secundaria
- Anemia leve
- Leucocitosis
- Trombocitosis
- Elevación de ESR y CRP
Son los sitios más frecuentemente afectados en la TB extrapulmonar
- Ganglios linfáticos
- Pleura
- Tracto genitourinario
- Huesos y articulaciones
- Meninges
- Peritoneo
- Pericardio
De acuerdo a la norma oficial mexicana, en cuanto al abordaje diagnóstico de TB, esta indicado realizar inicialmente las baciloscopias en serie de 3, en caso de que estas surgieran negativas en un paciente con un nivel de sospecha alto para TB, menciona cuales son los pasos a seguir?
- Realizar una nueva baciloscopia seriada en 3
- EN caso que resultaran de nuevo negativas, realizar cultivo
Es la TB extrapulmonar más común tanto en pacientes no-HIV como HIV positivos
Linfadenitis tuberculosa
Es el tipo de necrosis característica presente en el granuloma durante la fisiopatogenia de TB
Necrosis caseosa
Método diagnóstico para la linfadenitis tuberculosa
BAAF del ganglio afectado (comunmente cervicales o supraclaviculares)
Biopsia excisional
Cultivos positivos en el 70% de casos con observación de granulomas con/sin AFBs
Características clínicas, radiológicas y citológicas de una TB pleural
Se manifiesta como disnea, dolor pleurítico y derrame pleural
La toracocentesis es necesaria para el estudio citológico
Observando el líquido comunmente de color de paja, concentración protéica >50% en relación a suero (~4-6 g/dL), leucocitosis (500-6,000 cél/µL) predominio neutrófilos, glucosa normal o baja, y pH <7.3
La medición de los siguientes parámetros de laboratorio es de utilidad para descartar TB pleural en caso que se encuentre muy bajo o negativo
Adenosin deaminasa
IFN-¥
Son manifestaciones clínicas que incrementan la sospecha de una TB genitourinaria
CXR que demuestre cavitaciones o enfermedad pulmonar concomitante
Síntomas urológicos: Frecuencia, nocturia, disuria, hematuria, y dolor en flancos
Hallazgos de uroanalisis: Piuria, Hematuria, pH ácido de orina
Paciente de 56 años, DM2, HAS, con reciente inicio de disnea, tos productiva mucopurulente y perdida de peso, con hallazgo de cavitación en radiografía de tórax a nivel apical del pulmon derecho, inicia con sintomas urinarios disuria, hematuria, frecuencia y nocturia, y con uroanalisis que revela piuria y orina ácida. Se realiza MRI. ¿Cual es su impresión diagnóstica? ¿ cual estudio confirmaria su sospecha?

Es una posible tb genitourinaria, observandose lesiones de predominio medular a nivel del riñón derecho. Entre otras posibles lesiones observadas en imagenes de TB genitourinaria pueden ocurrir deformaciones renales, obstrucciones, calcificaciones y estrechamientos ureterales.
Se debe realizar la confirmación mediante un urocultivo seriado en 3 (tomados por las mañanas) para AFB.
¿Que patrón pulmonar se observa en la radiografía de tórax y que enfermedad sugiere?

Son infiltrados miliares bilaterales (en semilla de mijo) que hacen pensar en la tuberculosis miliar
Describe la imagen y el diagnóstico

Es un cultivo de Mycobacterium tuberculosis demostrando el bacilo acido-alcohol-resistente.
Descripción de la CT y posible diagnóstico
Se observa una cavitación en la zona apical del pulmon izquierdo que puede deberse a tuberculosis pulmonar secundaria o del adulto



